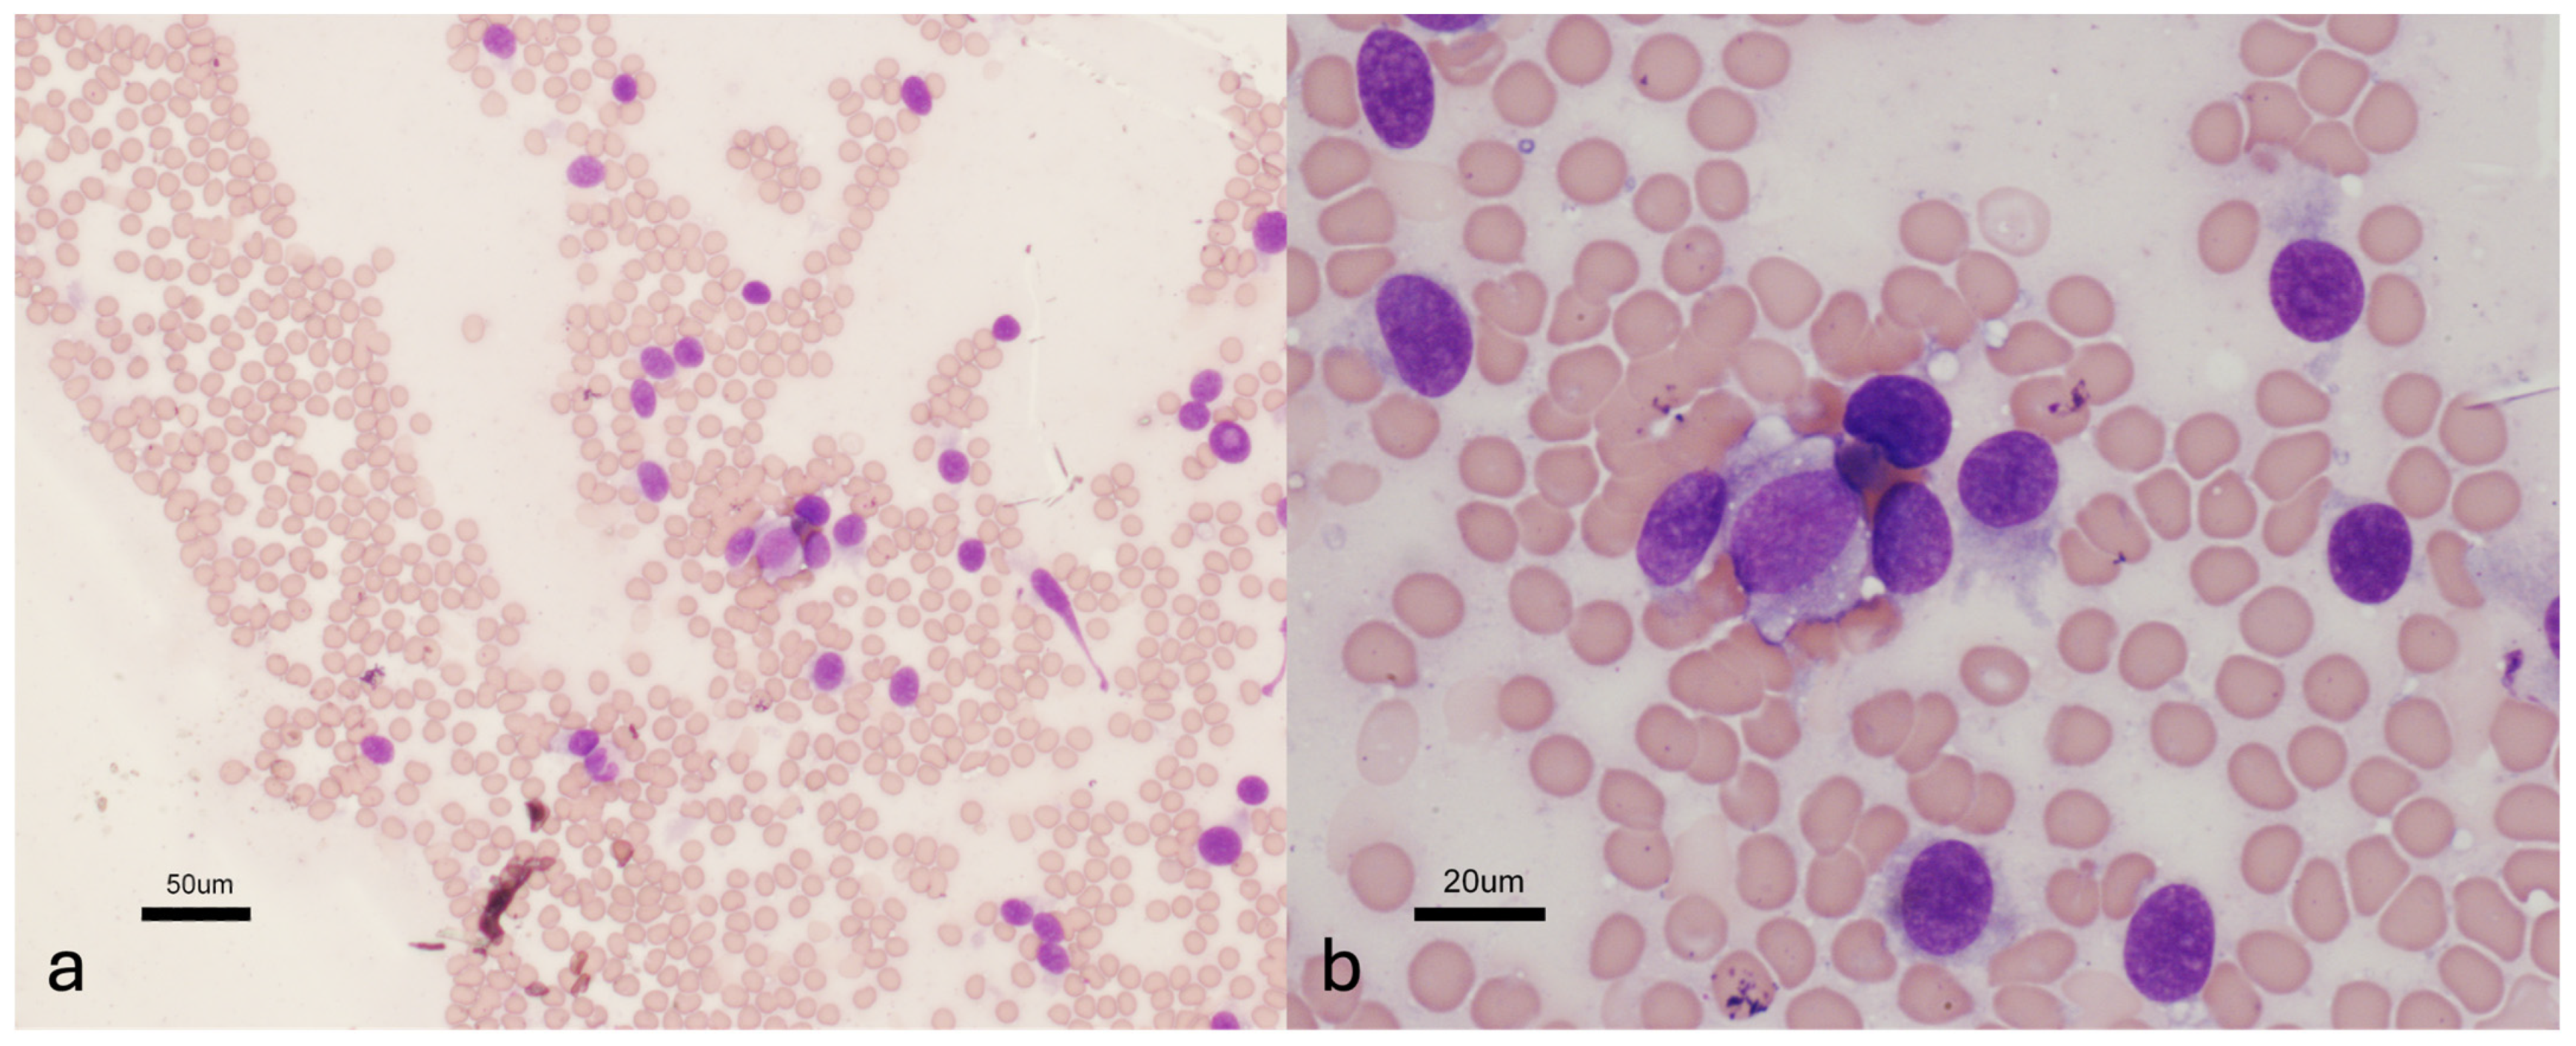
Vetsci 11 00192 g002

Clinical Findings and Outcome in 30 Dogs with Presumptive or Confirmed Nerve Sheath Tumors
Abstract
Simple Summary
Abstract
1. Introduction
2. Material and Methods
3. Results
3.1. Cranial NSTs
3.2. NSTs with Spinal Canal Invasion
3.3. NSTs External to the Spinal Canal
4. Discussion
5. Conclusions
Author Contributions
Funding
Institutional Review Board Statement
Informed Consent Statement
Data Availability Statement
Conflicts of Interest
References
- Rossmeisl, J.H.; Pancotto, T.E. Tumors of the nervous system. In Withrow and MacEwen’s Small Animal Clinical Oncology, 6th ed.; Vail, D.M., Thamm, D.H., Liptak, J.M., Eds.; Elsevier: St. Louis, MO, USA, 2020; p. 669. [Google Scholar]
- Stoica, G.; Tasca, S.I.; Kim, H.T. Point mutation of neu oncogene in animal peripheral nerve sheath tumors. Vet. Pathol. 2001, 38, 679–688. [Google Scholar] [CrossRef] [PubMed]
- Tekavec, K.; Svara, T.; Knific, T.; Gombac, M.; Cantile, C. Histopathological and immunohistochemical evaluation of canine nerve sheath tumors and proposal for an updated classification. Vet. Sci. 2022, 9, 204. [Google Scholar] [CrossRef] [PubMed]
- Chikkannaiah, P.; Boovalli, M.M.; Nathiyal, V.; Venkataramappa, S. Morphological spectrum of peripheral nerve sheath tumors: An insight into World Health Organization 2013 classification. J. Neurosci. Rural. Pract. 2016, 7, 346–354. [Google Scholar] [CrossRef] [PubMed]
- Brehm, D.M.; Vite, C.H.; Steinberg, H.S.; Haviland, J.; van Winkle, T. A retrospective evaluation of 51 cases of peripheral nerve sheath tumors in the dog. J. Am. Anim. Hosp. Assoc. 1995, 31, 349–359. [Google Scholar] [CrossRef] [PubMed]
- Bagley, R.S.; Wheeler, S.J.; Klopp, L.; Sorjonen, D.C.; Thomas, W.B.; Wilkens, B.E.; Gavin, P.R.; Dennis, R. Clinical features of trigeminal nerve-sheath tumor in 10 dogs. J. Am. Anim. Hosp. Assoc. 1998, 34, 19–25. [Google Scholar] [CrossRef]
- Bagley, R.S. Spinal neoplasms in small animals. Vet. Clin. N. Am. Small Anim. Pract. 2010, 40, 915–927. [Google Scholar] [CrossRef] [PubMed]
- Jones, B.R.; Alley, M.R.; Johnstone, A.C.; Jones, J.M.; Cahill, J.I.; McPherson, C. Nerve sheath tumors in the dog and cat. N. Z. Vet. J. 1995, 43, 190–196. [Google Scholar] [CrossRef] [PubMed]
- Bradley, R.L.; Withrow, S.J.; Snyder, S.P. Nerve sheath tumors in the dog. J. Am. Anim. Hosp. Assoc. 1982, 18, 915–921. [Google Scholar]
- Platt, S.R.; Graham, J.; Chrisman, C.L.; Collins, K.; Chandra, S.; Sirninger, J.; Newell, S.M. Magnetic resonance imaging and ultrasonography in the diagnosis of a malignant peripheral nerve sheath tumor in a dog. Vet. Radiol. Ultrasound 1999, 40, 367–371. [Google Scholar] [CrossRef]
- Yap, F.; Pratschke, K. Peripheral nerve sheath tumor of the vagus nerve in a dog. J. Am. Anim. Hosp. Assoc. 2016, 52, 57–62. [Google Scholar] [CrossRef]
- Giraud, L.; Lezmi, S.; Gomes, E.; Cauzinille, L. A rare case of malignant vagus nerve sheath tumor presenting with multiple cranial nerve dysfunction in a dog. Can. Vet. J. 2020, 61, 1049–1054. [Google Scholar] [PubMed]
- Biserni, R.; Bibbiani, L.; Mandara, M.T.; Balducci, F.; Amey, J.; Bernardini, M. Malignant nerve sheath tumor of the hypoglossal nerve in a maltese dog. J. Am. Anim. Hosp. Assoc. 2022, 58, 137–140. [Google Scholar] [CrossRef]
- Lacassagne, K.; Hearon, K.; Berg, J.; Séguin, B.; Hoyt, L.; Byer, B.; Selmic, L.E. Canine spinal meningiomas and nerve sheath tumours in 34 dogs (2008–2016): Distribution and long-term outcome based upon histopathology and treatment modality. Vet. Comp. Oncol. 2018, 16, 344–351. [Google Scholar] [CrossRef] [PubMed]
- Le Chevoir, M.; Thibaud, J.L.; Labruyère, J.; Uriarte, A.; De Fornel-Thibaud, P.; Moissonnier, P.; Delisle, F.; Blot, S. Electrophysiological features in dogs with peripheral nerve sheath tumors: 51 cases (1993–2010). J. Am. Anim. Hosp. Assoc. 2012, 241, 1194–1201. [Google Scholar] [CrossRef] [PubMed]
- Targett, M.P.; Dyce, J.; Houlton, J.E.F. Tumours involving the nerve sheaths of the forelimb in dogs. J. Small Anim. Pract. 1993, 34, 221–225. [Google Scholar] [CrossRef]
- Swift, K.E.; McGrath, S.; Nolan, M.W.; Young, M.; Reese, M.; Rao, S.; Randall, E.; Leary, D.; LaRue, S. Clinical and imagining findings, treatments, and outcomes in 27 dogs with imaging diagnosed trigeminal nerve sheath tumors: A multi-center study. Vet. Radiol. Ultrasound 2017, 38, 679–689. [Google Scholar] [CrossRef]
- Milodowski, E.J.; Amengual-Batle, P.; Beltran, E.; Gutierrez-Quintana, R.; De Decker, S. Clinical findings and outcome of dogs with unilateral masticatory muscle atrophy. J. Vet. Intern. Med. 2018, 33, 735–742. [Google Scholar] [CrossRef] [PubMed]
- Kraft, S.; Ehrhart, E.J.; Gall, D.; Klopp, L.; Gavin, P.; Tucker, R.; Bagley, R.; Kippenes, H.; DeHaan, C.; Pedroia, V.; et al. Magnetic resonance imaging characteristics of peripheral nerve sheath tumors of the canine brachial plexus in 18 dogs. Vet. Radiol. Ultrasound 2007, 48, 1–7. [Google Scholar] [CrossRef]
- Shultz, R.Y.; Tucker, R.L.; Gavin, P.R.; Bagley, R.; Saveraid, T.C.; Berry, C.R. Magnetic resonance imaging of acquired trigeminal nerve disorders in six dogs. Vet. Radiol. Ultrasound 2007, 48, 101–104. [Google Scholar] [CrossRef]
- Rose, S.; Long, C.; Knipe, M.; Hornof, B. Ultrasonographic evaluation of brachial plexus tumors in five dogs. Vet. Radiol. Ultrasound 2005, 46, 514–517. [Google Scholar] [CrossRef]
- Rudich, S.R.; Feeney, D.A.; Anderson, K.L.; Walter, P.A. Computed tomography of masses of the brachial plexus and contributing nerve roots in dogs. Vet. Radiol. Ultrasound 2004, 45, 46–50. [Google Scholar] [CrossRef]
- Kippenes, H.; Gavin, P.R.; Bagley, R.S.; Silver, G.M.; Tucker, R.L.; Sande, R.D. Magnetic resonance imaging features of tumors of the spine and spinal cord in dogs. Vet. Radiol. Ultrasound 1999, 40, 627–633. [Google Scholar] [CrossRef] [PubMed]
- Morabito, S.; Specchi, S.; Di Donato, P.; Pollard, D.; Dennis, R.; De Risio, L.; Bacon, N.J.; Potamopoulou, M.; Rupp, S.; Corlazzoli, D.; et al. Relationship between magnetic resonance imaging findings and histological grade in spinal peripheral nerve sheath tumors in dogs. J. Vet. Intern. Med. 2023, 37, 2278–2290. [Google Scholar] [CrossRef]
- Hansen, K.S.; Zwingenberger, A.L.; Théon, A.P.; Pfeiffer, I.; Kent, M.S. Treatment of MRI-diagnosed trigeminal peripheral nerve sheath tumors by stereotactic radiotherapy in dogs. J. Vet. Intern. Med. 2016, 30, 1112–1120. [Google Scholar] [CrossRef]
- Levy, M.S.; Kapatkin, A.S.; Patnaik, A.K.; Mauldin, G.N.; Mauldin, G.E. Spinal tumors in 37 dogs: Clinical outcome and long-term survival (1987–1994). J. Am. Anim. Hosp. Assoc. 1997, 33, 307–312. [Google Scholar] [CrossRef] [PubMed]
- Zwingenberger, A.L.; Pollard, R.E.; Taylor, S.L.; Chen, R.X.; Nunley, J.; Kent, M.S. Perfusion and volume response of canine brain tumors to stereotactic radiosurgery and radiotherapy. J. Vet. Intern. Med. 2016, 30, 827–835. [Google Scholar] [CrossRef]
- Besalti, O.; Caliskan, M.; Can, P.; Vural, S.A.; Algin, O.; Ahlat, O. Imaging and surgical outcomes of spinal tumors in 18 dogs and one cat. J. Vet. Sci. 2016, 17, 225–234. [Google Scholar] [CrossRef] [PubMed]
- Stokes, R.; Wustefeld-Janssens, B.G.; Hinson, W.; Wiener, D.J.; Hollenbeck, D.; Bertran, J.; Mickelson, M.; Chen, C.L.; Selmic, L.; Aly, A.; et al. Surgical and oncologic outcomes in dogs with malignant peripheral nerve sheath tumors arising from the brachial or lumbosacral plexus. Vet. Comp. Oncol. 2023, 21, 739–747. [Google Scholar] [CrossRef]
- Hendrick, M.J.; Mahaffey, E.A.; Moore, F.M.; Vos, J.H.; Walder, E.J. World Health Organization International Histological Classification of Tumors of Domestic Animals, Histological Classification of Mesenchymal Tumors of Skin and Soft Tissues of Domestic Animals, 2nd ed.; American Registry of Pathology: Washington, DC, USA, 1998; pp. 26–27. [Google Scholar]
- Kim, D.H.; Murovic, J.A.; Tiel, R.L.; Moes, G.; Kline, D.G. A series of 397 peripheral neural sheath tumors: 30-year experience at Louisiana State University Health Sciences Center. J. Neurosurg. 2005, 102, 246–255. [Google Scholar] [CrossRef]
- Kim, D.H.; Murovic, J.A.; Tiel, R.L.; Kline, D.G. Mechanisms of injury in operative brachial plexus lesions. Neurosurg. Focus 2004, 16, 1–8. [Google Scholar] [CrossRef]
- Ylä-Outinen, H.; Aaltonen, V.; Björkstrand, A.S.; Hirvonen, O.; Lakkakorpi, J.; Vähä-Kreula, M.; Laato, M.; Peltonen, J. Upregulation of tumor suppressor protein neurofibromin in normal human wound healing and in vitro evidence for platelet derived growth factor (PDGF) and transforming growth factor-β1 (TGF-β1) elicited increase in neurofibromin mRNA steady-state levels in dermal fibroblasts. J. Investig. Dermatol. 1998, 110, 232–237. [Google Scholar] [PubMed]
- Ferner, R.E.; Gutmann, D.H. International consensus statement on malignant peripheral nerve sheath tumors in neurofibromatosis 1. Cancer Res. 2002, 62, 1573–1577. [Google Scholar] [PubMed]
- Bathla, G.; Hegde, A.N. The trigeminal nerve: An illustrated review of its imaging anatomy and pathology. Clin. Radiol. 2013, 68, 203–213. [Google Scholar] [CrossRef] [PubMed]
- Evans, H.E.; de Lahunta, A. Miller’s Anatomy of the Dog, 4th ed.; Elsevier: St. Louis, MO, USA, 2013; pp. 712–721. [Google Scholar]
- Bowers, C.A.; Taussky, P.; Duhon, B.S.; Chin, S.S.; Couldwell, W.T. Malignant peripheral nerve sheath tumour of the trigeminal nerve: Case report and literature review. Br. J. Neurosurg. 2011, 25, 750–753. [Google Scholar] [CrossRef] [PubMed]
- Schmidt, R.F.; Yick, F.; Boghani, Z.; Eloy, J.A.; Liu, J.K. Malignant peripheral nerve sheath tumors of the trigeminal nerve: A systematic review of 36 cases. Neurosurg. Focus 2013, 34, E5. [Google Scholar] [CrossRef] [PubMed]
- L’heureux-Lebeau, B.; Saliba, I. Updates on the diagnosis and treatment of intracranial nerve malignant peripheral nerve sheath tumors. Onco. Targets Ther. 2013, 6, 459–470. [Google Scholar] [PubMed]
- Scheithauer, B.W. Development of the WHO classification of tumors of the central nervous system: A historical perspective. Brain Pathol. 2009, 19, 551–564. [Google Scholar] [CrossRef]
- Hours, M.; Bernard, M.; Arslan, M.; Montestrucq, L.; Richardson, L.; Deltour, I.; Cardis, E. Can loud noise cause acoustic neuroma? Analysis of the INTERPHONE study in France. Occup. Environ. Med. 2009, 66, 480–486. [Google Scholar] [CrossRef] [PubMed]
- Scheifele, P.; Martin, D.; Clark, J.G.; Kemper, D.; Wells, J. Effect of kennel noise on hearing in dogs. Am. J. Vet. Res. 2012, 73, 482–489. [Google Scholar] [CrossRef]
- Schneider, D.C.; Foss, K.D.; De Risio, L.; Hague, D.W.; Mitek, A.E.; McMichael, M. Noise-induced hearing loss in 3 working dogs. Top Companion Anim. Med. 2019, 37, 100362. [Google Scholar] [CrossRef]
- McCarthy, R.J.; Feeney, D.A.; Lipowitz, A.J. Preoperative diagnosis of tumors of the brachial plexus by use of computed tomography in three dogs. J. Am. Vet. Med. Assoc. 1993, 202, 291–294. [Google Scholar] [CrossRef] [PubMed]
- da Costa, R.C.; Parent, J.M.; Dobson, H.; Ruotsalo, K.; Holmberg, D.; Duque, M.C.; Poma, R. Ultrasound-guided fine needle aspiration in the diagnosis of peripheral nerve sheath tumors in 4 dogs. Can. Vet. J. 2008, 49, 77–81. [Google Scholar] [PubMed]
- Wheeler, S.J.; Jones, D.G.C.; Wright, J.A. The diagnosis of brachial plexus disorders in dogs: A review of twenty-two cases. J. Small Anim. Pract. 1986, 27, 147–157. [Google Scholar] [CrossRef]
- Dolera, M.; Malfassi, L.; Marcarini, S.; Mazza, G.; Carrara, N.; Pavesi, S.; Sala, M.; Finesso, S.; Urso, G. High dose hypofractionated frameless volumetric modulated arc radiotherapy is a feasible method for treating canine trigeminal nerve sheath tumors. Vet. Radiol. Ultrasound 2018, 59, 624–631. [Google Scholar] [CrossRef] [PubMed]
- van Stee, L.; Boston, S.; Teske, E.; Meij, B. Compartmental resection of peripheral nerve tumours with limb preservation in 16 dogs (1995–2011). Vet. J. 2017, 226, 40–45. [Google Scholar] [CrossRef]
- Mariani, C.L.; Schubert, T.A.; House, R.A.; Wong, M.A.; Hopkins, A.L.; Barnes Heller, H.L.; Milner, R.J.; Lester, N.V.; Lurie, D.M.; Rajon, D.A.; et al. Frameless stereotactic radiosurgery for the treatment of primary intracranial tumours in dogs. Vet. Comp. Oncol. 2015, 13, 409–423. [Google Scholar] [CrossRef]

| Dog | Age (y) | Mass Location | Intracranial Clinical Signs | Intracranial Extension on MRI | Duration of Signs (wk) | Presumptive or Confirmed Diagnosis | Treatment | Definitive Treatment Details | Outcome | Survival Time (mo) |
|---|---|---|---|---|---|---|---|---|---|---|
| 1 | 4 | CN IX, X, XI | Yes | Yes | 12 | Confirmed | None | Euthanasia | 0.07 | |
| 2 | 12 | CN IX, X, XI | Yes | Yes | 4 | Presumptive | Palliative | Euthanasia | 4 | |
| 3 | 6 | Right CN V | No | No | 40 | Confirmed | Palliative | Euthanasia | 23 | |
| 4 | 10 | Left CN V | No | No | 3 | Presumptive | Definitive | Definitive RT | Euthanasia | 32 |
| 5 | 7 | Left CN V | Yes | Yes | 2 | Presumptive | Palliative | Euthanasia | 4 | |
| 6 | 11 | Right CN V | Yes | Yes | 52 | Presumptive | Palliative | Euthanasia | 0.75 | |
| 7 | 10 | Right CN V | No | No | 12 | Presumptive | Palliative | Euthanasia | 5 | |
| 8 | 8 | Left CN V | No | Yes | 52 | Presumptive | Definitive | Definitive RT | Lost to follow-up | >18 * |
| Dog | Age (y) | Mass Location | Spinal Cord Clinical Signs | Mass Location within Canal on MRI | Duration of Signs (wk) | Presumptive or Confirmed Diagnosis | Treatment | Definitive Treatment Details | Outcome | Survival Time (mo) |
|---|---|---|---|---|---|---|---|---|---|---|
| 1 | 12 | Right C1–C2 | Yes | I + E | 1.4 | Presumptive | Definitive | Definitive RT | Euthanasia | 0.75 |
| 2 | 7 | Right C1–C2 | Yes | I + E | 2 | Presumptive | Palliative | Euthanasia | 0.14 | |
| 3 | 8 | Right C2–C3 | Yes | I + E | 7 | Confirmed | Definitive | Debulking surgery + RT | Euthanasia | 3.5 |
| 4 | 9 | Right C2–C3 | Yes | I + E | 3.5 | Presumptive | None | Euthanasia | 0 | |
| 5 | 6 | Left C3–C4 | Yes | E | 6 | Presumptive | Palliative | Euthanasia | 1 | |
| 6 | 12 | Left C3–C4 | I + E | 52 | Presumptive | Palliative | Euthanasia | 0.5 | ||
| 7 | 8 | Right C4–C5 | Yes | I + E | 6 | Presumptive | Palliative | Euthanasia | 2 | |
| 8 | 5 | Left C6–C7 | No | I + E | 16 | Presumptive | Palliative | Euthanasia | 0.75 | |
| 9 | 9 | Left C6–C7 | Yes | I | 0.7 | Presumptive | Palliative | Euthanasia | 0.11 | |
| 10 | 11 | Left C7 | Yes | I + E | 8 | Presumptive | Palliative | Lost to follow-up | 0 * | |
| 11 | 11 | Left T1–T3 | Yes | I | 12 | Presumptive | Palliative | Euthanasia | 0.11 | |
| 12 | 6 | Right C7–T2 | Yes | I + E | 16 | Presumptive | Palliative | Euthanasia | 0.18 | |
| 13 | 11 | Right T2–T3 | No | I + E | 4 | Presumptive | Palliative | Lost to follow-up | >2 ** |
| Dog | Age (y) | Mass Location | Foraminal Extension on MRI | Duration of Signs (wk) | Presumptive or Confirmed Diagnosis | Treatment | Definitive Treatment Details | Outcome | Survival Time (mo) |
|---|---|---|---|---|---|---|---|---|---|
| 1 | 13 | Right brachial plexus | No | 36 | Presumptive | Palliative | Euthanasia | 14.5 | |
| 2 | 8 | Right brachial plexus | No | 8 | Presumptive | Palliative | Euthanasia | 0.11 | |
| 3 | 11 | Left brachial plexus | No | 8 | Presumptive | Definitive | Definitive RT | Euthanasia | 5 |
| 4 | 5 | Right C7–T1 nerve roots | Yes | 44 | Confirmed | Palliative | Euthanasia | 1 | |
| 5 | 9 | Left C8–T1 nerve roots | No | 16 | Presumptive | Palliative | Euthanasia | 7 | |
| 6 | 10 | Right C8–T1 nerve roots | Yes | 52 | Presumptive | Palliative | Euthanasia | 4 | |
| 7 | 4 | Left T1 nerve root | No | 24 | Confirmed | Definitive | Amputation | Euthanasia | 52 |
| 8 | 8 | Right L7 nerve root | Yes | 8 | Presumptive | Palliative | Euthanasia | 0.75 | |
| 9 | 8 | Left L7 nerve root | No | 1 | Presumptive | Palliative | Euthanasia | 10 |
Disclaimer/Publisher’s Note: The statements, opinions and data contained in all publications are solely those of the individual author(s) and contributor(s) and not of MDPI and/or the editor(s). MDPI and/or the editor(s) disclaim responsibility for any injury to people or property resulting from any ideas, methods, instructions or products referred to in the content. |
© 2024 by the authors. Licensee MDPI, Basel, Switzerland. This article is an open access article distributed under the terms and conditions of the Creative Commons Attribution (CC BY) license (https://creativecommons.org/licenses/by/4.0/).
Share and Cite
Cooper-Khan, R.S.; Frankovich, A.N.; Thompson, C.A.; Thomovsky, S.A.; Lewis, M.J. Clinical Findings and Outcome in 30 Dogs with Presumptive or Confirmed Nerve Sheath Tumors. Vet. Sci. 2024, 11, 192. https://doi.org/10.3390/vetsci11050192
Cooper-Khan RS, Frankovich AN, Thompson CA, Thomovsky SA, Lewis MJ. Clinical Findings and Outcome in 30 Dogs with Presumptive or Confirmed Nerve Sheath Tumors. Veterinary Sciences. 2024; 11(5):192. https://doi.org/10.3390/vetsci11050192
Chicago/Turabian StyleCooper-Khan, Rachel S., Alexandra N. Frankovich, Craig A. Thompson, Stephanie A. Thomovsky, and Melissa J. Lewis. 2024. "Clinical Findings and Outcome in 30 Dogs with Presumptive or Confirmed Nerve Sheath Tumors" Veterinary Sciences 11, no. 5: 192. https://doi.org/10.3390/vetsci11050192
APA StyleCooper-Khan, R. S., Frankovich, A. N., Thompson, C. A., Thomovsky, S. A., & Lewis, M. J. (2024). Clinical Findings and Outcome in 30 Dogs with Presumptive or Confirmed Nerve Sheath Tumors. Veterinary Sciences, 11(5), 192. https://doi.org/10.3390/vetsci11050192

